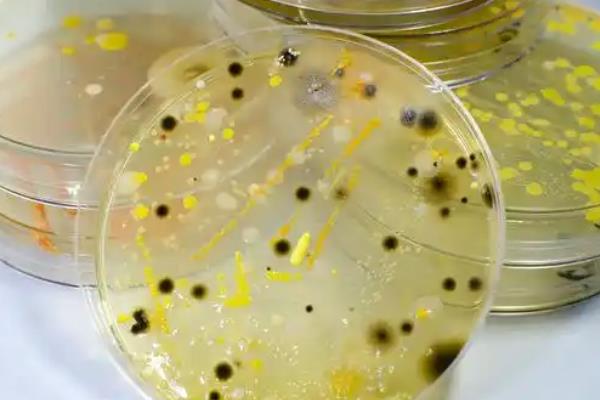
如何自己在家培养菌种，接种时在培养料的表面覆盖菌种
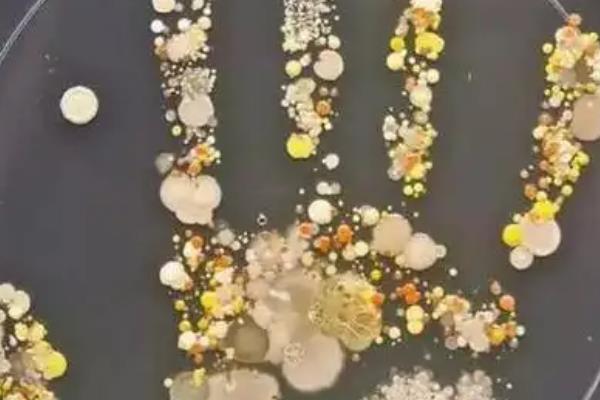
如何自己在家培养菌种，接种时在培养料的表面覆盖菌种

准备培养基:配方为木屑77.8%、石膏与糖各1%、麸皮20%、杀菌剂0.2%。
配制培养基:把培养料放在水泥地上,用铁锹反复搅拌。再往水盆里加入糖与杀菌剂,反复搅动至完全溶解。
装料与灭菌:选质量优异且韧性较强的聚丙烯塑料袋装料,装料后,扎紧袋口,进行常压灭菌。
接种培养菌种:接种时,尽可能在培养料的表面上,覆盖菌种,接种后,扎紧袋口。

一、如何自己在家培养菌种
1、准备培养基
原种、母种、栽培种培养基为配方为木屑77.8%、石膏1%、麸皮20%、糖1%、杀菌剂0.2%。

2、配制培养基
(1)按照配方比例称取配料,将木屑、石膏、麸皮等干培养料放在水泥地面上,用铁锹反复搅拌。
(2)按料水比称取干净的冷水倒入塑料盆内,再将糖、杀菌剂添加至水中,然后用木棍反复搅动,直至完全溶解。
3、装料与灭菌
用质量优异、韧性较强的聚丙烯塑料袋装料,装料应紧密适中,装完后扎紧袋口,然后进行常压灭菌。

4、接种培养菌种
接种时,可尽可能在培养料的表面覆盖菌种,使菌种优先占据材料表面,形成生长优势(快速萌发可控制杂菌),接种后马上将袋口扎紧即可。

二、菌种的脱毒方法
1、菌种的脱毒,通常可借鉴植物的脱毒技术。所谓植物脱毒,是将植物茎尖生长尖端组织进行分离,将分离组织置于特定培养基中进行培养,从而获得脱离原体病毒、病菌的新生种苗。
2、具体的脱毒方式有菌丝尖端脱毒法、原基组织脱毒法等。脱毒菌种恢复了菌种原有的生物特性,使菌种的抗性得到了增强,抗病力得到了提高。
3、菌丝尖端脱毒法,通常使用规格为90mm或110mm的培养皿,无此规格培养皿时,可改用规格为25mm*200mm的大型试管,但操作不太方便。
4、原基组织脱毒技术,最大程度革除了原有组织分离时子实体处于生长中后期携带病毒、病菌可能性极大等弊端,真正实现了分离尖端组织脱毒的目的。
声明:本文由作者上传并发布,农服务网仅提供信息发布平台,文章仅代表作者个人观点,不代表农服务网立场,内容旨在传播知识,若有内容错误或侵权等问题请及时与本网站联系,我们将在第一时间作更正或删除处理。